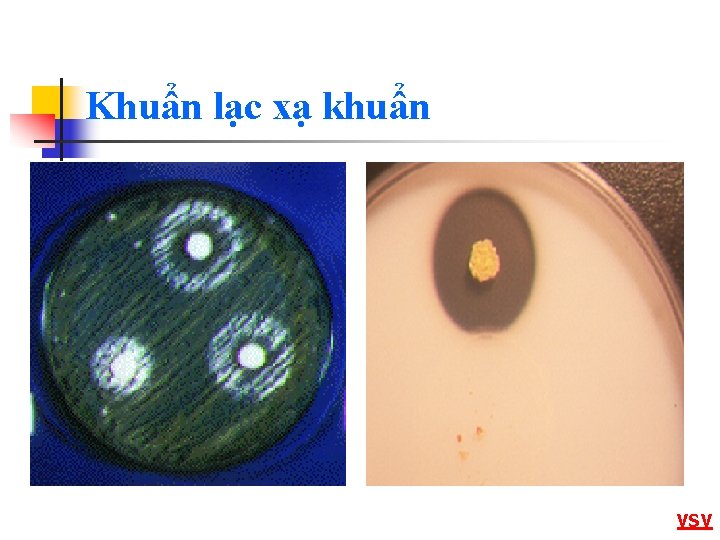
Khuẩn lạc xạ khuẩn VSV

THC HNH QUAN ST HNH NH V MT

- Slides: 46
THỰC HÀNH QUAN SÁT HÌNH ẢNH VỀ MỘT SỐ VI SINH VẬT 1
Hình ảnh về một số VSV 1. Vi khuẩn (Bacteria) 2. Xạ khuẩn (Actinomycetes) 3. Vi khuẩn lam (Cyanobacteria) 4. Vi nấm (Microfungi) 5. Tảo (Algae) 6. Động vật nguyên sinh (Protozoa) 7. Một số nhà VSV học
Vi khuẩn (Bacteria) n n n Là VSV nhân nguyên thuỷ (nhân sơ) Có nhiều hình thái, kích thước và cách sắp xếp khác nhau Kích thước: 0, 2 -2, 0µm 2, 0 -8, 0µm Hình dạng: hình cầu, hình que, hình xoắn, hình có cuống, hình sợi. . . Đa số sinh sản bằng phân đôi VSV
Cầu khuẩn (Coccus) n n n Là những vi khuẩn rất phổ biến Không có khả năng chuyển động Tuỳ theo phương hướng, mặt phẳng phân cách và cách liên kết: n Đơn cầu khuẩn (Micrococcus) n Song cầu khuẩn (Diplococcus) n Liên cầu khuẩn (Streptococcus) n Bát cầu khuẩn (Sarcina) n Tụ cầu khuẩn (Staphylococcus)
Đơn cầu khuẩn (Micrococcus) n n n M. flavus Tế bào phân chia theo 1 mp Đa số sống hoại sinh trong đất, nước, không khí 1 số loài có khả năng sinh sắc tố làm hỏng thực phẩm: M. flavus (st vàng), M. roceus (st hồng)
Song cầu khuẩn (Diplococcus) n n Neisseria menigitidis Phân chia theo 1 mp, các tb dính với nhau từng đôi 1 số loài gây bệnh: viêm phổi (D. pneumoniae), viêm tai giữa, viêm màng não cầu khuẩn (Neisseria menigitidis), bệnh lậu (Neisseria gonorrhoeae)
Bát cầu khuẩn (Sarcina) n n S. ventriculi Tế bào phân chia theo 3 mp, tạo thành khối 8 hay 16 tế bào Đại diện: S. ventriculi (lên men rượu)
Liên cầu khuẩn (Streptococcus) n n n S. pyogenes Tế bào phân chia theo 1 mp, các tế bào con dính nhau thành chuỗi Phân bố rộng rải trong tự nhiên 1 số gây bệnh: viêm họng (S. pyogenes), một số có lợi: S. lactis
Tụ cầu khuẩn (Staphylococcus) n n n Staphylococus aureus Phân chia theo nhiều mp bất kì, các tế bào tụ thành từng đám Thường gặp trên niêm mạc, da Một số gây bệnh: ngộ độc thịt (S. aureus), bại huyết, viêm khớp ở gia cầm VK
Trực khuẩn n n Có dạng hình que ngắn Hầu hết chuyển động được nhờ tiêm mao Có khả năng tạo bào tử khi gặp điều kiện bất lợi Bao gồm: n Bacillus Clostridium n Escherichia Pseudomonas
Bacillus n n n B. anthracis Vk Gr(+), có khả năng sinh bào tử Hiếu khí hoặc kị khí không bắt buộc Đa số gây bệnh: nhiệt thán (B. anthracis), ngộ độc thức ăn (B. cereus), làm hỏng thực phẩm rau hộp (B. coagulaus)
Escherichia n n n Escherichia coli Vk Gr(-), không có khả năng sinh bào tử, có tiêm mao mọc xung quanh Sống hoại sinh trong thực phẩm, trong ruột người và đv Đd: E. coli gây viêm ruột tiêu chảy
Clostridium n n n Cl. botulium Vk Gr(+), có khả năng sinh bào tử Sống trong đất, ruột người và đv, một số có khả năng gây bệnh Đd: Cl. botulinum (gây ngộ độc thịt), Cl. tetani (gây uốn ván)
Pseudomonas n n n Pseudomonas Vk Gr(-), không sinh bào tử, có một chùm tiêm mao ở 1 cực Có khả năng sinh sắc tố vàng, đỏ, trắng, làm hỏng thực phẩm. 1 số gây bệnh ở người Đd: Ps. fluorescens (làm hỏng thực phẩm)
S. lactis S. pneumonie S. pneumoniae D. gonorrhoeae
Mycobacterium tuberculosis E. coli B. anthracis B. cereus
C. tetani Shigella spp P. fluorescens VK
Xoắn khuẩn n n Gồm một số ít vi sinh vật Tuỳ vào hình dạng xoắn, chia ra: n Phẩy khuẩn (Vibrio) n Xoắn thưa - Xoắn khuẩn (Spirillum) n Xoắn khít - Xoắn thể (Spirochaetes)
Phẩy khuẩn (Vibrio) n n n V. cholera Cơ thể xoắn chưa đến nửa vòng, giống như dấu phẩy, có tiêm mao mọc ở đỉnh, rất di động Một số sống hoại sinh, số khác ký sinh Điển hình là VK tả (Vibrio cholera), Vibrio comma
Xoắn khuẩn (Spirillum) n n S. volutans Vi khuẩn Gr(+) Cơ thể xoắn từ một vòng đến nhiều vòng, có một hay nhiều tiêm mao mọc ở đỉnh Đa số sống hoại sinh, phân giải cặn hữu cơ có ích Có rất nhiều trong răng miệng
Xoắn thể (Spirochaeta) n n n Spirochaeta Có hình một sợi xoắn, kích thước tương đối lớn (5 -100µm) Không có tiêm mao, di chuyển bằng cách trườn, thành tế bào đàn hồi Đd: Vk giang mai, Vk gây sốt hồi quy VK
Xạ khuẩn (Actinomycetes) n n n Là VSV nhân nguyên thuỷ, cùng nhóm với VK Có khả năng tạo ra kháng sinh và nhiều chất hữu cơ quý Khi nuôi cấy trên mt đặc, XK phát triển thành một đám gọi là khuẩn lạc. Mỗi khuẩn lạc gồm 2 hệ khuẩn ty (hệ sợi): n Hệ khuẩn ty khí sinh: phát triển trên bề mặt cơ chất theo hình phóng xạ xạ khuẩn n Hệ khuẩn ty cơ chất: phát triển trong cơ chất, có nhiệm vụ lấy nước và chất dinh dưỡng
Khuẩn lạc xạ khuẩn VSV
Vi khuẩn lam (Cyanobacteria) n n Anabaena cylindrica Spirulina Là VSV nhân nguyên thuỷ, có chứa lục lạp quang hợp Phân bố rộng trong tự nhiên, được xem như những sinh vật tiên phong Hình dạng: đơn bào, đa bào hình sợi Nhiều loại có giá trị cao, nuôi cấy để thu sinh khối (Spirulina), hoặc có khả năng cố định nitơ (Anabaena azollae) VSV
Vi nấm (Microfungi) n n n Là những VSV nhân thật Đa số sống hoại sinh, một số sống kí sinh, số ít sống cộng sinh với tảo Bao gồm: n Nấm men (Yeast) n Nấm sợi (Filamentous fungi)
Nấm men (Yeast) n n n Saccharomyces cerevisiae Tồn tại ở trạng thái đơn bào Đa số sinh sản theo kiểu nảy chồi Thích nghi với mt chứa đường cao, p. H thấp Hình dạng: cầu, trứng, ôvan, thoi … Có khoảng 483 loài thuộc 66 chi khác nhau Đd: Nấm men rượu (S. cerevisiae)
Nấm sợi (filamentous fungi) n n n Rhizopus Sinh sản bằng bào tử Cấu tạo hình sợi phân nhánh, sinh trưởng ở đỉnh, phát triển thành đám hệ khuẩn ty Chia 2 loại: n Bậc thấp: khuẩn ty không có vách ngăn (Rhizopus, Mucor) n Bậc cao: khuẩn ty có vách ngăn (Aspergillus, Penicillium)
Rhizopus Mucor
Penicillium Aspergillus VSV
Tảo (Algae) n n Là những thực vật bậc thấp, đơn bào hay đa bào, cơ thể không phân hoá thành rễ, thân, lá, không có mạch dẫn Sống tự dưỡng nhờ có diệp lục Phần lớn sống trong nước, một số sống trên cạn ở đất, đá, vỏ cây Chia thành nhiều ngành dựa vào màu sắc và nguồn gốc: Tảo silic, Tảo nâu, Tảo đỏ, Tảo lục, Tảo vòng …
Tảo vòng Tảo silic (Navicula) Tảo lục
Tảo lục (Volvox) Tảo lục (Netrium digitus) VSV
ĐV nguyên sinh (Protozoa) n n n Là những VSV nhân thật, đơn bào, cơ thể phân hoá phức tạp tào thành những cơ quan tử đảm nhận các chức phận khác nhau Chủ yếu sinh sản vô tính: phân đôi, liệt sinh, mọc chồi, một số sinh sản hữu tính Dựa vào phương thức vận chuyển, chia 4 lớp chính: trùng biến hình, trùng roi, trùng cỏ, trùng bào tử
Amoeba proteus Paramoecium caudatum Euglena viridis Plasmodium vivax
VSV
Một số nhà VSV học
Một số nhà VSV học
Antonie van Leeuwenhoek (1632 -1723) n n n Sinh ra tại Hà Lan Là người đầu tiên quan sát VSV Các nghiên cứu của ông được trình bày trong tác phẩm “Những bí mật của giới tự nhiên nhìn qua KHV” (gồm 4 tập) kh 1
Robert Koch (1843 -1910) n n Một bác sĩ người Đức Là người đề xuất phương pháp nhuộm màu VSV 1881, ông đưa ra phương pháp phân lập thuần khiết VSV, dùng gelatin và thạch làm MT nuôi cấy 1882 -1883, phân lập được VK lao và VK tả kh 1
Louis Pasteur (1822 -1895) n n Sinh ra tại tp Đô-lơ, miền đông nước Pháp Các nghiên cứu chính của ông: n 1857 -Sự lên men n 1860 -Bác bỏ thuyết tự sinh n 1865 -Bệnh của rượu vang và bia n 1868 -Các bệnh tằm n 1881 -VSV gây bệnh và vacxin n 1885 -Phòng ngừa bệnh dại kh 2
Ilia Ilitch Metchnikov (1845 -1916) n n n Sinh ra tại tỉnh Khacop, thuộc Ucraina hiện nay 1884, phát hiện khả năng thực bào của bạch cầu 1908, đạt giải Nobel về y học kh 2
Sinh sản ở nấm NS
Sinh sản ở nấm Nấm von (Fusarium moniliforme) NS
Sinh sản ở nấm NS
Một số khái niệm n n n Cộng sinh: là quan hệ giữa các SV khác loài, cả hai bên đều có lợi, phụ thuộc lẫn nhau. Hoại sinh: phương thức dinh dưỡng của vi khuẩn, nấm bằng cách phân huỷ những hợp chất hữu cơ có sẵn và hấp thụ chúng Kí sinh: là quan hệ giữa các SV khác loài, loài này dùng cơ thể loài kia làm môi trường sống và nguồn dinh dưỡng Liệt sinh: hình thức sinh sản vô tính ở trùng bào tử, từ một tế bào mẹ phân chia thành nhiều phần nhỏ. Tiêm mao (flageles): là những sợi nguyên sinh chất mảnh, giúp cho vi khuẩn chuyển đông theo hướng. Khi tiêm mao ngắn thì gọi là tiên mao.
Câu hỏi thu hoạch 1. 2. 3. VSV gồm những nhóm nào? Đặc điểm của mỗi nhóm VSV? Kể tên một số đại diện của mỗi nhóm VSV.